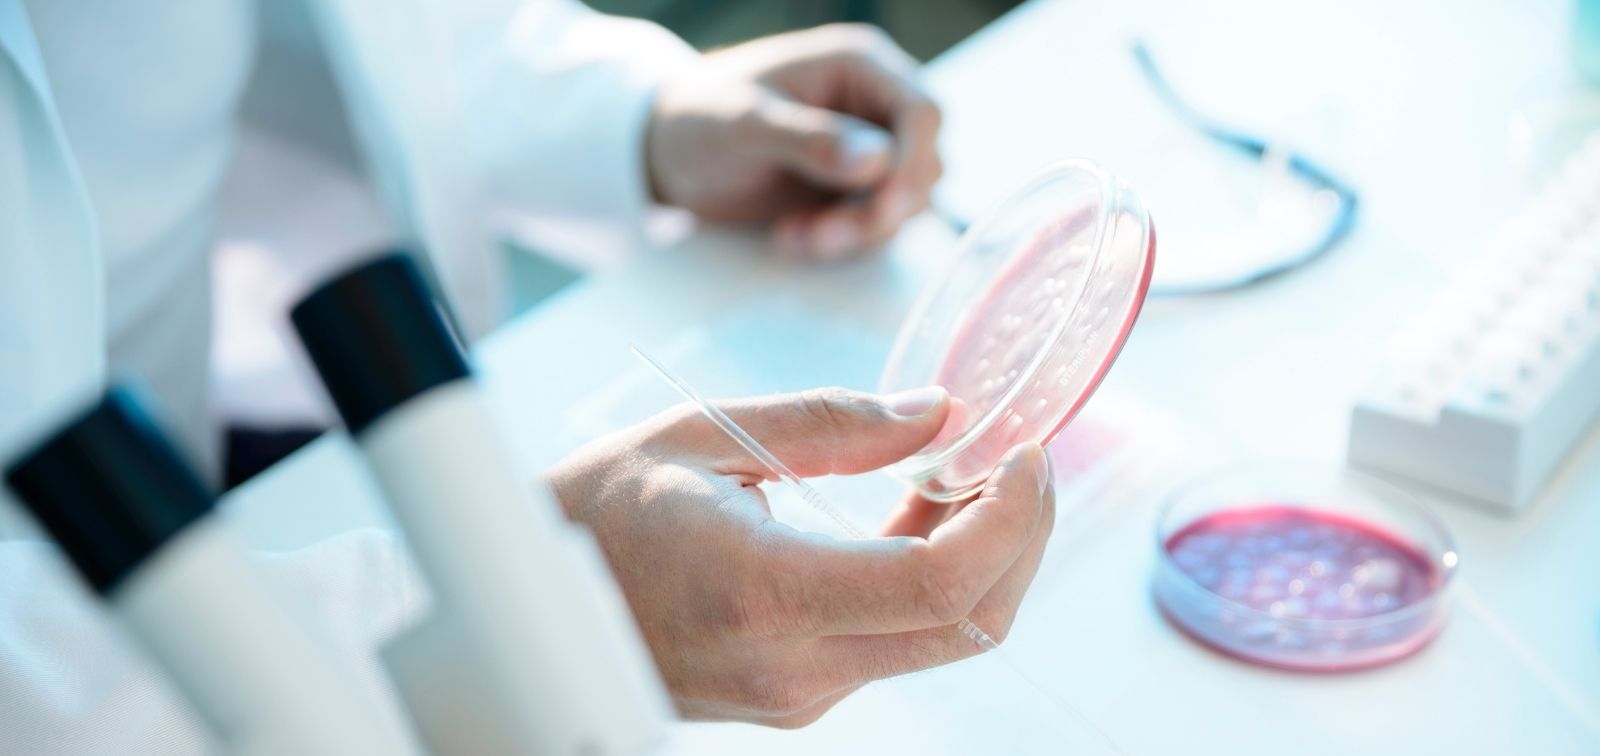

Els plasmidis dirigits, una eina biotecnològica que obre noves vies contra la resistència als antimicrobians
Mitjançant la tecnologia CRISPR-Cas, eliminen o resensibilitzen soques multiresistents d'E. coli sense afectar la microbiota intestinal
10.03.2026
Els plasmidis antibacterians dirigits (Targeted Antibacterial Plasmids, TAP) es perfilen com una eina prometedora per descolonitzar l’intestí de bacteris multiresistents sense alterar els bacteris beneficiosos. Aquesta és la principal conclusió d’un estudi publicat a Nucleic Acid Research, elaborat per l’Institut de Salut Global de Barcelona (ISGlobal), centre impulsat per la Fundació ”la Caixa”, en col·laboració amb l’institut francès INSERM del Centre National de la Recherche Scientifique (CNRS) de França.
La resistència als antimicrobians (RAM) és una de les principals amenaces per a la salut pública: el 2019 es van associar 3,57 milions de morts a infeccions resistents, prop d’un milió directament atribuïbles a elles. La manca de nous antibiòtics eficaços agreuja aquest problema i obliga a cercar alternatives innovadores.
El tracte intestinal acull una comunitat complexa de microorganismes coneguda com a microbiota. Hi conviuen bacteris comensals, que afavoreixen l’absorció de nutrients i actuen com a barrera davant patògens, i bacteris potencialment patògens, com certes soques d’Escherichia coli (E. coli). Quan bacteris multiresistents als antibiòtics colonitzen aquest entorn, augmenta el risc d’infeccions posteriors, especialment en persones immunodeprimides. El principal repte és desenvolupar una estratègia antibacteriana capaç d’eliminar exclusivament les soques resistents als antimicrobians sense afectar altres espècies comensals beneficioses.
Els plasmidis antibacterians dirigits i el sistema CRISPR-Cas
Un plasmidi és una petita cadena d’ADN circular independent del cromosoma bacterià. Els plasmidis antibacterians dirigits (TAP) són eines biotecnològiques dissenyades per combatre de manera selectiva la resistència als antibiòtics. A diferència dels antibiòtics convencionals, que actuen sobre un ampli espectre de bacteris, els TAP reconeixen i ataquen només els bacteris que porten un gen de resistència específic.
Per fer-ho, utilitzen la conjugació bacteriana, un mecanisme natural de transferència d’ADN, per introduir-se en el bacteri resistent. Un cop dins, els TAP expressen un sistema CRISPR-Cas programat per identificar una seqüència concreta d’ADN bacterià i provocar la mort del bacteri resistent o fer que perdi la resistència a l’antibiòtic.
Utilitzant els TAP per eliminar o ressensibilitzar soques d’E. coli
“En aquest estudi avaluem el potencial dels TAP davant unes soques bacterianes multiresistents: les E. coli productores d’ESBL (Extended-Spectrum Beta-Lactamases), que són enzims que les fan resistents a la majoria d’antibiòtics betalactàmics, incloent penicil·lines i cefalosporines. Aquestes soques porten el gen blaCTX-M-15, un dels determinants més comuns de resistència”, explica Natalia Roson-Calero, investigadora a ISGlobal i coautora de l’estudi.
L'eliminació o ressensibilització d’aquests bacteris és especialment rellevant, ja que els enterobacteris resistents a cefalosporines de tercera generació estan classificats com a patògens crítics per l’OMS, per la seva elevada càrrega de malaltia i les limitades opcions terapèutiques disponibles. L’estudi es va centrar, en particular, en el clon d’alt risc ST131, un dels llinatges més prevalents i virulents.
“Quan el TAP incorporava Cas9 –un enzim que actua com a tisora molecular– provocava ruptures de doble cadena en el gen blaCTX-M-15. Si el gen estava en el cromosoma, el dany era letal i el bacteri moria ràpidament. Si estava en un plasmidi, el tall provocava la pèrdua d’aquest plasmidi i, amb ella, de la resistència”, explica Roson-Calero. “En alguns casos, aquesta pèrdua activava sistemes toxina–antitoxina (TA) associats al mateix plasmidi, cosa que també podia causar la mort del bacteri”.
Tanmateix, l’equip investigador va observar que els TAP basats en una altra versió de l’enzim, la dCas9, no trencaven l’ADN. En lloc d’això, bloquejaven la transcripció del gen blaCTX-M-15, impedint que es produís la proteïna responsable de la resistència. Com a resultat, el bacteri recuperava la sensibilitat als antibiòtics sense que la seva viabilitat es veiés compromesa directament.
L’objectiu: eliminar només les soques resistents
En cultius mixtos, els TAP van eliminar específicament les E. coli portadores de blaCTX-M-15 sense afectar altres espècies bacterianes presents. A més, en assaigs de conjugació realitzats en femtes humanes (un entorn microbiana complex i més proper a la situació clínica) tant els TAP-Cas9 com els TAP-dCas9 van aconseguir suprimir significativament les E. coli resistents a cefotaxima.
“Els nostres resultats reforcen el potencial dels TAP com a eina de descolonització selectiva de l’intestí. A més, obren la porta a futures estratègies d’edició dirigida del microbioma per prevenir la disseminació o la infecció per bacteris multiresistents”, conclou Jordi Vila, Research Professor i investigador al grup de Resistència Antimicrobiana d’ISGlobal.
Referència
Derollez, E., Roson-Calero, N., Rouzé, P., Dedieu-Berne, A., Ballesté-Delpierre, C., Fraikin, N., Iorga, B. I., Huang, T.-D., Bigot, S., Vila, J., Bogaerts, P., & Lesterlin, C. (2026). Specific killing and resensitization of pathogenic Escherichia coli strains carrying blaCTX-M-15 β-lactamase using targeted-antibacterial-plasmids (TAPs). Nucleic Acids Research, 54(1). https://doi.org/10.1093/nar/gkaf1466

